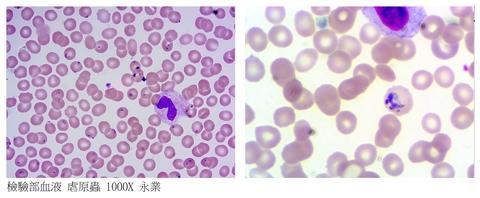

Taiwantrade.com and iDealEZ.com uses analytical cookies and other tracking technologies to offer you the best possible user experience. By using our website, you acknowledge and agree to our cookie policy.
For more information on cookies or changing your cookies settings, read Taiwantrade & iDealEZ’s Privacy Policy.